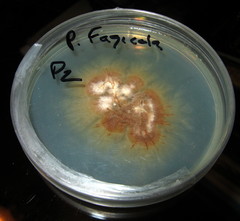
Psilocybe yungensis

Psilocybe yungensis: taxon details and analytics
- Domain
- Kingdom
- Fungi
- Phylum
- Basidiomycota
- Class
- Agaricomycetes
- Order
- Agaricales
- Family
- Hymenogastraceae
- Genus
- Psilocybe
- Species
- Psilocybe yungensis
- Scientific Name
- Psilocybe yungensis
Summary description from Wikipedia:
Psilocybe yungensis
Psilocybe yungensis is a species of psychedelic mushroom in the family Hymenogastraceae. In North America, it is found in northeast, central and southeastern Mexico. In South America, it has been recorded from Bolivia, Colombia, and Ecuador. It is also known from the Caribbean island Martinique, and China. The mushroom grows in clusters or groups on rotting wood. The fruit bodies have conical to bell-shaped reddish- to orangish-brown caps that are up to 2.5 cm (1.0 in) in diameter, set atop slender stems 3 to 5 cm (1.2 to 2.0 in) long. The mushrooms stain blue when bruised, indicative of the presence of the compound psilocybin. Psilocybe yungensis is used by Mazatec Indians in the Mexican State of Oaxaca for entheogenic purposes.
...Images from inaturalist.org observations:
We recommend you sign up for this excellent, free service.
Parent Taxon
Sibling Taxa
- Cordisporae
- Psilocybe acutipilea
- Psilocybe acutissima
- Psilocybe aequatoriae
- Psilocybe albofimbriata
- Psilocybe allenii
- Psilocybe alnetorum
- Psilocybe alpina
- Psilocybe alutacea
- Psilocybe angulospora
- Psilocybe apelliculosa
- Psilocybe arcana
- Psilocybe argentina
- Psilocybe argentipes
- Psilocybe atlantis
- Psilocybe aucklandiae
- Psilocybe australiana
- Psilocybe aztecorum
- Psilocybe azurescens
- Psilocybe baeocystis
- Psilocybe banderillensis
- Psilocybe barrerae
- Psilocybe blattariopsis
- Psilocybe bohemica
- Psilocybe borealis
- Psilocybe brasiliensis
- Psilocybe bulbosa
- Psilocybe bullacea
- Psilocybe caeruleoannulata
- Psilocybe caerulescens
- Psilocybe caerulipes
- Psilocybe castillotovarii
- Psilocybe chilensis
- Psilocybe chuxiongensis
- Psilocybe cinnamomea
- Psilocybe clavata
- Psilocybe cubensis
- Psilocybe cyanescens
- Psilocybe cyanofibrillosa
- Psilocybe cylindrispora
- Psilocybe dumontii
- Psilocybe egonii
- Psilocybe fagicola
- Psilocybe farinacea
- Psilocybe fasciata
- Psilocybe fimetaria
- Psilocybe fuliginosa
- Psilocybe furtadoana
- Psilocybe fuscofulva
- Psilocybe gallaeciae
- Psilocybe germanica
- Psilocybe graveolens
- Psilocybe guilartensis
- Psilocybe heimii
- Psilocybe herrerae
- Psilocybe hispanica
- Psilocybe hoogshagenii
- Psilocybe hopii
- Psilocybe jacobsii
- Psilocybe jaliscana
- Psilocybe josecastilloi
- Psilocybe keralensis
- Psilocybe kumaenorum
- Psilocybe laticystis
- Psilocybe latispora
- Psilocybe liniformans
- Psilocybe magica
- Psilocybe magnispora
- Psilocybe makarorae
- Psilocybe mammillata
- Psilocybe medullosa
- Psilocybe meridionalis
- Psilocybe mescaleroensis
- Psilocybe mesophylla
- Psilocybe mexicana
- Psilocybe modesta
- Psilocybe moseri
- Psilocybe muliercula
- Psilocybe musci
- Psilocybe naematoliformis
- Psilocybe natalensis
- Psilocybe neoxalapensis
- Psilocybe novozoncuantlensis
- Psilocybe oaxacana
- Psilocybe ovoideocystidiata
- Psilocybe panaeoliformis
- Psilocybe papuana
- Psilocybe paupera
- Psilocybe pegleriana
- Psilocybe pelliculosa
- Psilocybe pintonii
- Psilocybe pleurocystidiosa
- Psilocybe plutonia
- Psilocybe pratensis
- Psilocybe pseudobullacea
- Psilocybe rzedowskii
- Psilocybe samuiensis
- Psilocybe sanctorum
- Psilocybe schultesii
- Psilocybe semilanceata
- Psilocybe serbica
- Psilocybe silvatica
- Psilocybe singeri
- Psilocybe singeriana
- Psilocybe singularis
- Psilocybe strictipes
- Psilocybe stuntzii
- Psilocybe subaeruginascens
- Psilocybe subaeruginosa
- Psilocybe subcaerulipes
- Psilocybe subcubensis
- Psilocybe subfimetaria
- Psilocybe subhoogshagenii
- Psilocybe subpsilocybioides
- Psilocybe subtropicalis
- Psilocybe subyungensis
- Psilocybe subzapotecorum
- Psilocybe tampanensis
- Psilocybe tasmaniana
- Psilocybe teofiloi
- Psilocybe thaiaerugineomaculans
- Psilocybe thaicordispora
- Psilocybe thaiduplicatocystidiata
- Psilocybe thaizapoteca
- Psilocybe tuxtlensis
- Psilocybe uxpanapensis
- Psilocybe verae-crucis
- Psilocybe washingtonensis
- Psilocybe wassoniorum
- Psilocybe wayanadensis
- Psilocybe weldenii
- Psilocybe weraroa
- Psilocybe xalapensis
- Psilocybe yungensis
- Psilocybe zapotecoantillarum
- Psilocybe zapotecorum
- Psilocybe zoncuantlensis